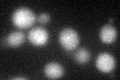
YPL008W
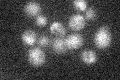
YPL008W

View description
Conserved nuclear protein required to establish sister-chromatid pairing during S-phase, probable DNA helicase with similarity to human BACH1, which associates with tumor suppressor BRCA1; associates with acetyltransferase Ctf7p
Localization:
Intensity:
Fold change:
Significance:
-
C’ GFP library in SD

nucleus16.68 -
N' NOP1pr-GFP in SD

nucleus51.0147 -
N' TEF2pr-mCherry in SD

nucleus53.7777 -
N' NATIVEpr-GFP in SD

below threshold20.5281 -
N' TEF2pr-VC and Cyto-VN in SD

nucleus31.6673 -
C’ GFP library in SD+DTT
nucleus19.781.18No -
C’ GFP library in SD+H2O2

nucleus14.520.87No -
C’ GFP library in Starvation Media
nucleus17.241.03No -
C’ GFP library on the background of Pup2-DaMP

nucleus -
C’ GFP library on the background of CCT mutant

nucleus16.14790.967738No
